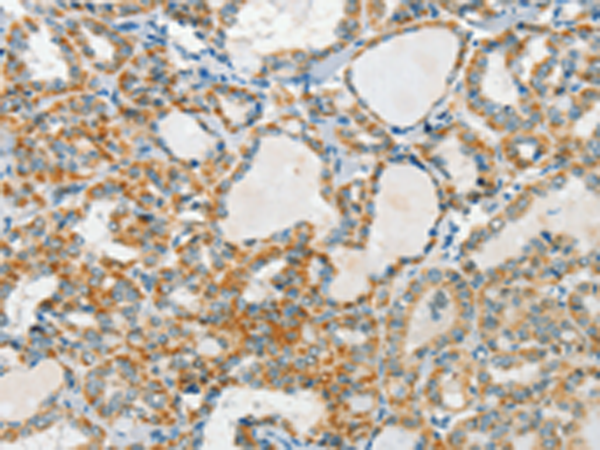

中文名稱: 兔抗AANAT多克隆抗體
英文名稱: Anti-AANAT rabbit polyclonal antibody
別 名: DSPS; SNAT
儲 存: 冷凍(-20℃)
宿 主: Rabbit
反應(yīng)種屬: Human, Mouse, Rat
標 記 物: Unconjugate
克隆類型: rabbit polyclonal
技術(shù)規(guī)格
|
Background: |
The protein encoded by this gene belongs to the acetyltransferase superfamily. It is the penultimate enzyme in melatonin synthesis and controls the night/day rhythm in melatonin production in the vertebrate pineal gland. Melatonin is essential for the function of the circadian clock that influences activity and sleep. This enzyme is regulated by cAMP-dependent phosphorylation that promotes its interaction with 14-3-3 proteins and thus protects the enzyme against proteasomal degradation. This gene may contribute to numerous genetic diseases such as delayed sleep phase syndrome. Alternatively spliced transcript variants encoding different isoforms have been found for this gene. |
|
Applications: |
ELISA, IHC |
|
Name of antibody: |
AANAT |
|
Immunogen: |
Fusion protein of human AANAT |
|
Full name: |
aralkylamine N-acetyltransferase |
|
Synonyms: |
DSPS; SNAT |
|
SwissProt: |
Q16613 |
|
ELISA Recommended dilution: |
1000-5000 |
|
IHC positive control: |
Human thyroid cancer and Human cervical cancer |
|
IHC Recommend dilution: |
50-200 |
購物車
購物車 幫助
幫助
 021-54845833/15800441009
021-54845833/15800441009
